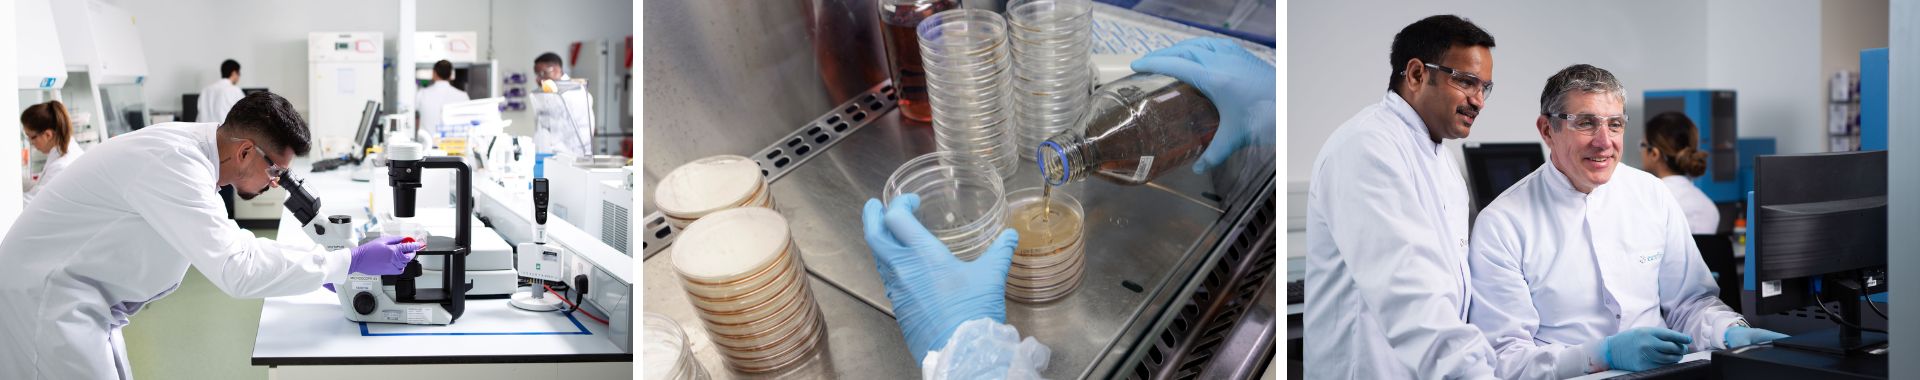
Burkholderia Cepacia Complex Eurofins BPT France

Recherche ou dénombrement de Burkholderia Cepacia Complex
Contactez-nous
Burkholderia Cepacia Complex (BCC) est composé d’au moins 21 espèces difficiles à identifier et à différencier, d’où leur regroupement au sein de ce complexe.
Certaines de ces espèces sont parmi les contaminant les plus fréquemment rencontrés dans les produits pharmaceutiques stériles ou non-stériles. Ils sont l’une des principales causes de rappel de lots de produits pharmaceutiques pour des raisons microbiologiques.
De plus, 3 des espèces de ce complexe (B. cepacia, B. multivorans, B. cenocepacia) sont responsables d’infections graves chez l’homme, particulièrement pour les personnes atteintes de mucoviscidose ou immunodéprimées.
Nos services
Nos laboratoires prennent en charge cette problématique de A à Z.
Détection et identification des espèces du complexe Burkholderia Cepacia (BCC)
- Dans les réseaux d’eau
- Dans les matières premières
- Dans les produits finis
- Sur les surfaces en zones de production
- Dans les désinfectants
Une offre de service complète
- Fertilité des milieux
- Recherche de BCC dans les produits pharmaceutiques selon USP <60>
- Identification précise à l’espèce grâce aux techniques spécifiquement développées
- Recherche de la présence de BCC dans les lots de désinfectants
- Investigation au niveau des réseaux d'eau et des surfaces
- Comparaison des souches par typage moléculaire pour identifier les sources de contamination
- Conseil dans le cadre global de la maitrise de la contamination (Annexe 1 des BPF)
- Production de souches de références
Pour tout savoir sur le complexe Burkholderia Cepacia, retrouvez notre article « Burkholderia Cepacia a encore frappé » écrit par Arnaud Carlotti, publié dans La Vague n°64.
Nous contacter
Si vous souhaitez travailler avec Eurofins sur un projet BioPharma, remplissez le formulaire de contact, nos équipes vous contacteront dans les meilleurs délais.
Merci pour votre demande